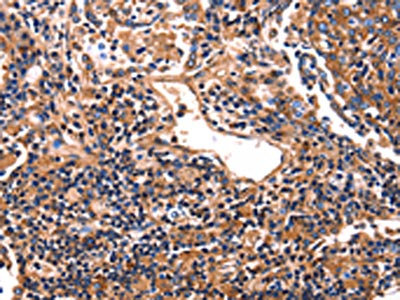

HP Antibody
-
中文名稱:HP兔多克隆抗體
-
貨號:CSB-PA568452
-
規格:¥1100
-
圖片:
-
The image on the left is immunohistochemistry of paraffin-embedded Human lung cancer tissue using CSB-PA568452(HP Antibody) at dilution 1/25, on the right is treated with fusion protein. (Original magnification: ×200)
-
The image on the left is immunohistochemistry of paraffin-embedded Human tonsil tissue using CSB-PA568452(HP Antibody) at dilution 1/25, on the right is treated with fusion protein. (Original magnification: ×200)
-
Gel: 10%SDS-PAGE, Lysate: 30 μg, Lane: Human brain glioma tissue, Primary antibody: CSB-PA568452(HP Antibody) at dilution 1/400, Secondary antibody: Goat anti rabbit IgG at 1/8000 dilution, Exposure time: 5 seconds
-
-
其他:
產品詳情
-
Uniprot No.:
-
基因名:
-
別名:Binding peptide antibody; BP antibody; Haptoglobin alpha chain antibody; Haptoglobin alpha(1S) beta antibody; Haptoglobin alpha(2FS) beta antibody; Haptoglobin beta chain antibody; Haptoglobin, alpha polypeptide antibody; Haptoglobin, beta polypeptide antibody; HP antibody; HP2 ALPHA2 antibody; HP2ALPHA2 antibody; HPA1S antibody; HPT antibody; HPT_HUMAN antibody; MGC111141 antibody; Zonulin antibody
-
宿主:Rabbit
-
反應種屬:Human,Mouse,Rat
-
免疫原:Fusion protein of Human HP
-
免疫原種屬:Homo sapiens (Human)
-
標記方式:Non-conjugated
-
抗體亞型:IgG
-
純化方式:Antigen affinity purification
-
濃度:It differs from different batches. Please contact us to confirm it.
-
保存緩沖液:-20°C, pH7.4 PBS, 0.05% NaN3, 40% Glycerol
-
產品提供形式:Liquid
-
應用范圍:ELISA,WB,IHC
-
推薦稀釋比:
Application Recommended Dilution ELISA 1:1000-1:5000 WB 1:200-1:1000 IHC 1:25-1:100 -
Protocols:
-
儲存條件:Upon receipt, store at -20°C or -80°C. Avoid repeated freeze.
-
貨期:Basically, we can dispatch the products out in 1-3 working days after receiving your orders. Delivery time maybe differs from different purchasing way or location, please kindly consult your local distributors for specific delivery time.
-
用途:For Research Use Only. Not for use in diagnostic or therapeutic procedures.
相關產品
靶點詳情
-
功能:As a result of hemolysis, hemoglobin is found to accumulate in the kidney and is secreted in the urine. Haptoglobin captures, and combines with free plasma hemoglobin to allow hepatic recycling of heme iron and to prevent kidney damage. Haptoglobin also acts as an antioxidant, has antibacterial activity, and plays a role in modulating many aspects of the acute phase response. Hemoglobin/haptoglobin complexes are rapidly cleared by the macrophage CD163 scavenger receptor expressed on the surface of liver Kupfer cells through an endocytic lysosomal degradation pathway.; The uncleaved form of allele alpha-2 (2-2), known as zonulin, plays a role in intestinal permeability, allowing intercellular tight junction disassembly, and controlling the equilibrium between tolerance and immunity to non-self antigens.
-
基因功能參考文獻:
- findings suggest that rs5471 is a strong genetic determinant of HP levels in Ghanaians, and this seems to be characteristic of Africans PMID: 29772214
- We report on the identification of a novel 72 kd Hb reactive species which is cross-linked to HDL and demonstrate that vitamin E in HDL is decreased in Hp 2-2 diabetes mellitus individuals. PMID: 29888289
- zonulin appears not to be an inflammatory marker in CKD. It seems it also does not play a role in the disturbances of iron metabolism in CKD. Its physiological role remains to be elucidated. PMID: 29134616
- High serum Haptoglobin levels, but not Hp1-Hp2 polymorphism is associated with polycystic ovary syndrome. PMID: 28900795
- Hp 2-2 phenotype is an independent predictor of postoperative acute kidney injury and is associated with decreased short and long-term survival after cardiac surgery in patients with diabetes mellitus. PMID: 28982674
- Due to its fluctuation, a single measurement of zonulin level is not recommended for assessment of intestinal barrier integrity. PMID: 28883692
- Review/Meta-analysis: No association was found between the Hp gene variants and retinopathy in type 2 diabetics. PMID: 28758129
- This study investigates the involvement of Hp glycosylation in gastric cancer. It examined the site-specific glycosylation of serum Hp, revealing the feasibility of glycoproteomic profiling as a powerful platform for potential diagnostic markers with high sensitivity and high specificity for gastric cancer. PMID: 29285644
- Differentially expressed haptoglobin can serve as a potential biomarker for type 2 diabetic mellitus in the American Hispanic population. PMID: 28218436
- identified that apolipoprotein-A1 and haptoglobin had significant predictive values for the prediction of recovery at 12 weeks in DILI, enabling the construction of a new prognostic panel, the DILI-ActiTest, which needs to be independently validated PMID: 29287080
- HP genetic variation may have utility as a biomarker of insulin resistance and diabetes risk in Arab-Americans. PMID: 29039222
- Given the importance of Hp glycosylation, its unknown and unclear biological complexity and significances, Hp glycosylation has become a major target in cancer research. Development of sensitive and specific detection of Hp glycosylation including large-scale validation may be significant steps forward to its clinical application. PMID: 26873173
- Data suggest that serum haptoglobin may act as useful clinical serological biomarkers in progression and prognostic evaluation in non-small cell lung cancer (NSCLC). PMID: 27248178
- Although better control may reduce the incidence of coronary artery disease in Type 1 diabetes, a residual risk related to the haptoglobin 2 allele remains. PMID: 27028131
- Regardless of the haptoglobin genotype, haptoglobin is associated with prevention of endothelial cell apoptosis in diabetes. PMID: 28830235
- study discovered a splice donor founder mutation in HP (NM_001126102.1:c.190 + 1G > C); this mutation occurs on the HP1 allele of the common copy number variant in HP and leads to loss of function of HP1; it associates with lower levels of haptoglobin, higher levels of non-high density lipoprotein cholesterol and greater risk of coronary artery disease PMID: 28398513
- the minor allele (T) of rs8062041 appeared to be protective against African Trypanosomiasis; haptoglobin related protein (HPR) is adjacent to HP and is a component of the Trypanolytic factor; the HP and HPR locus is duplicated in some people; the rs8062041 variant may be associated with this duplication and it is possible that increased production of HPR is the cause of protection associated with rs806204 PMID: 29077717
- These results suggest that the hippocampus of Hp 1-1 genetic carriers may be more vulnerable to the insults of poor glycemic control. PMID: 28860127
- Our results show an association between increased early-pregnancy serum zonulin concentration and gestational diabetes, suggesting zonulin as a possible predictor for gestational diabetes. PMID: 28319108
- Pilot study shows an association of the haptoglobin 2-2 genotype with low-grade inflammation, haptoglobin concentration and carotid artery intima-media thickness in multi-ethnic population from Singapore. PMID: 27190085
- We conducted a replication study using a dataset outside of the Challenge, and found the association between TP53INP2 and ER-negative breast cancer was significant (p = 5.07x10-3). Expression of HP (16q22.2) showed a suggestive association with ER-negative breast cancer in the discovery phase (Z = 4.30, p = 1.70x10-5) although the association was not significant after Bonferroni adjustment. PMID: 28957356
- Studies suggest an association of serum haptoglobin N-glycan variation with gastric cancer and might be a promising marker for the cancer screening. PMID: 28052004
- These results were consistent with the data of the clinical specimens. miR-122a could be a positive factor of zonulin by targeting EGFR, which increased the intestinal epithelial permeability in vivo and in vitro. PMID: 28641303
- Hp2 allele is associated with premature ischemic cardiovascular deaths after first-ever ischemic stroke. PMID: 28487337
- Vitamin E may provide benefit in reducing cardiovascular disease in haptoglobin Hp2-2 genotype individuals with diabetes. PMID: 28451949
- High serum levels of HP at baseline are associated with inadequate response of 12 weeks methotrexate treatment in recent-onset rheumatoid arthritis patients. PMID: 24863583
- Celiac disease (CD) is associated with elevation of the circulating zonulin level, the value of which correlates with the density of enteroviruses in CD patients with severe atrophic changes in the small bowel mucosa, particularly in cases of concomitant type 1 diabetes. PMID: 27995404
- Results show that zonulin was significantly higher in obese children when compared to healthy children, indicating a potential role of zonulin in the etiopathogenesis of obesity and related disturbances. PMID: 28008865
- Our findings suggest that increased serum zonulin concentration, i.e., increased intestinal permeability, contributes to metabolic endotoxemia, systemic inflammation, and insulin resistance in overweight pregnant women PMID: 28285651
- The present study demonstrated that the mRNA and protein expression levels of haptoglobin were increased in patients with psoriasis. PMID: 27571879
- SCC-specific HP peptide HP216 may have a role in lung squamous cell carcinoma and could be a serum biomarker PMID: 26783151
- Altered glycosylation, expression of serum haptoglobin and alpha-1-antitrypsin in chronic hepatitis C, hepatitis C induced liver cirrhosis and hepatocellular carcinoma patients. PMID: 27034286
- In addition to predicting the incidence of cardio-renal complications, HP 2-2 also increases susceptibility for cardio-renal mortality in type 1 diabetes. PMID: 26684170
- Findings suggest that the antioxidative and anti-inflammatory capacity of the Hp 2 is inferior to that of the Hp 1 allele. PMID: 26114833
- The ratio of the fucosylated peaks to their corresponding nonfucosylated forms shows that the fucosylated glycans from haptoglobin are upregulated in the case of hepatocellular carcinoma samples versus cirrhosis samples. PMID: 26503433
- The bifucosylated tetra-anntenary glycan of haptoglobin was upregulated in hepatocellular carcinoma patients of all etiologies. PMID: 26448449
- Ovarian cancer cells express both Hp and its receptor CCR2 but only after exposure to ascitic fluid, inducing moderated cell migration; results suggest that Hp-induced changes in the cell morphology, actin cytoskeleton structure, and migration ability of tumor cells, is possibly "preparing" these cells for the potential induction of the metastatic phenotype. PMID: 26211665
- Haptoglobin phenotype is unlikely to be an important modifier of cystic fibrosis phenotype. PMID: 26370551
- Recurring exonic deletions in HP likely enhance human health by lowering cholesterol levels in the blood. PMID: 26901066
- these results demonstrate that sHP is associated with poor prognosis of colorectal cancer patients and that HP promotes colorectal cancer cell invasion. PMID: 26756179
- Haptoglobin 2-2 genotype was an independent predictor of cerebral salt wasting syndrome after subarachnoid hemorrhage. PMID: 26348010
- Endothelial dysfunction may be influenced by Hp2/2 genotype in patients with type 1 diabetes with independence of classical CV risk factors. PMID: 26122942
- This study suggests a possible role of haptoglobin phenotype on iron metabolism abnormalities that are observed in Parkinson disease. PMID: 26228081
- The present study described differentially expressed human haptoglobin as a lung cancer serum protein biomarker, which may serve as a diagnostic and therapeutic target. PMID: 26005016
- Hp 2 type is associated with elevated systolic pulmonary arterial pressure and low plasma nitrite levels in hemodialysis patients specifically in the diabetes mellitus state. PMID: 26171400
- Serum levels of haptoglobin are higher in pancreatic cancer patients. PMID: 25861849
- Patients with type 2 diabetes and poor glycaemic control carrying the Hp 1-1 genotype may be at increased risk of cognitive impairment, particularly in the attention/working memory domain. PMID: 25628235
- Structure of the human Hp-Hb and Trypanosoma brucei brucei HpHbR protein complex is described. PMID: 25410714
- Report increased numbers of highly fucosylated Haptoglobin alpha isoforms in ascitic fluids and the presence of fucosylated Haptoglobin in tumor tissues of ovarian cancer Mexican patients associated with advanced stages of the disease. PMID: 24576319
- Serum zonulin levels are significantly elevated in newly diagnosed Chinese Type 2 diabetes patients, indicating a potential role of zonulin in the pathophysiology of type 2 diabetes in Chinese. PMID: 25238913
顯示更多
收起更多
-
相關疾病:Anhaptoglobinemia (AHP)
-
亞細胞定位:Secreted.
-
蛋白家族:Peptidase S1 family
-
組織特異性:Expressed by the liver and secreted in plasma.
-
數據庫鏈接:
Most popular with customers
-
YWHAB Recombinant Monoclonal Antibody
Applications: ELISA, WB, IHC, IF, FC
Species Reactivity: Human, Mouse, Rat
-
Phospho-YAP1 (S127) Recombinant Monoclonal Antibody
Applications: ELISA, WB, IHC
Species Reactivity: Human
-
-
-
-
-
-